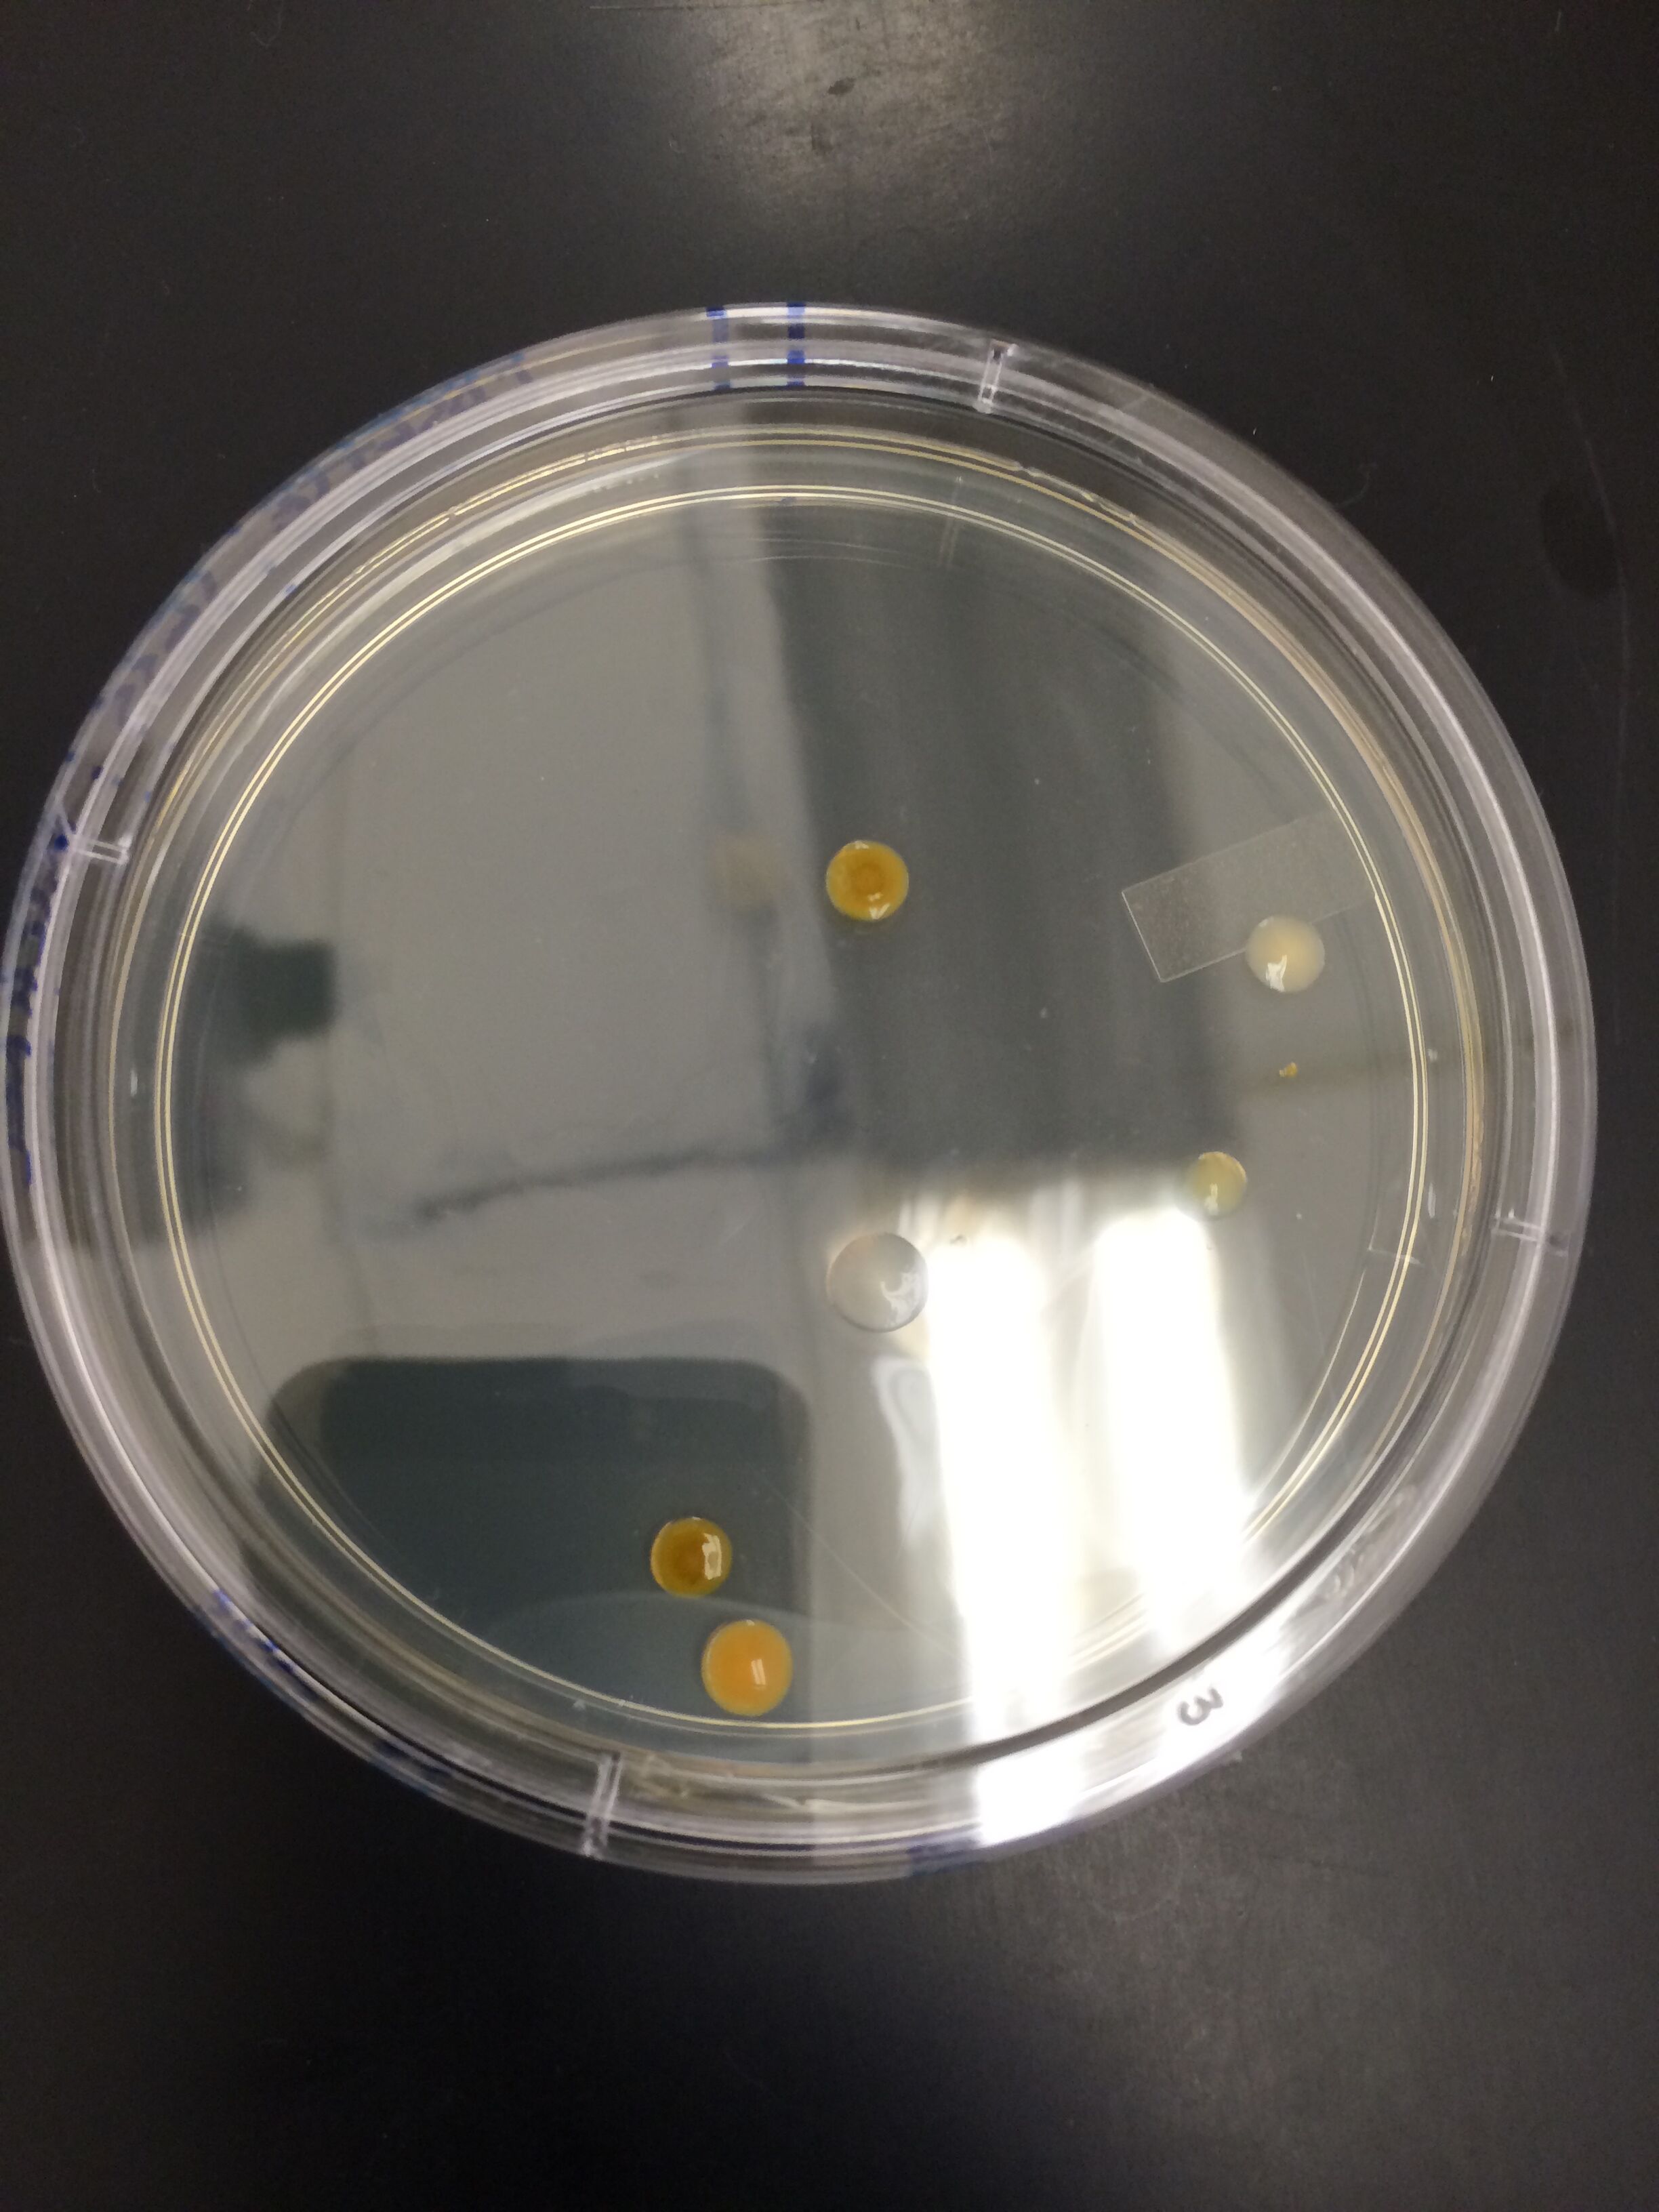
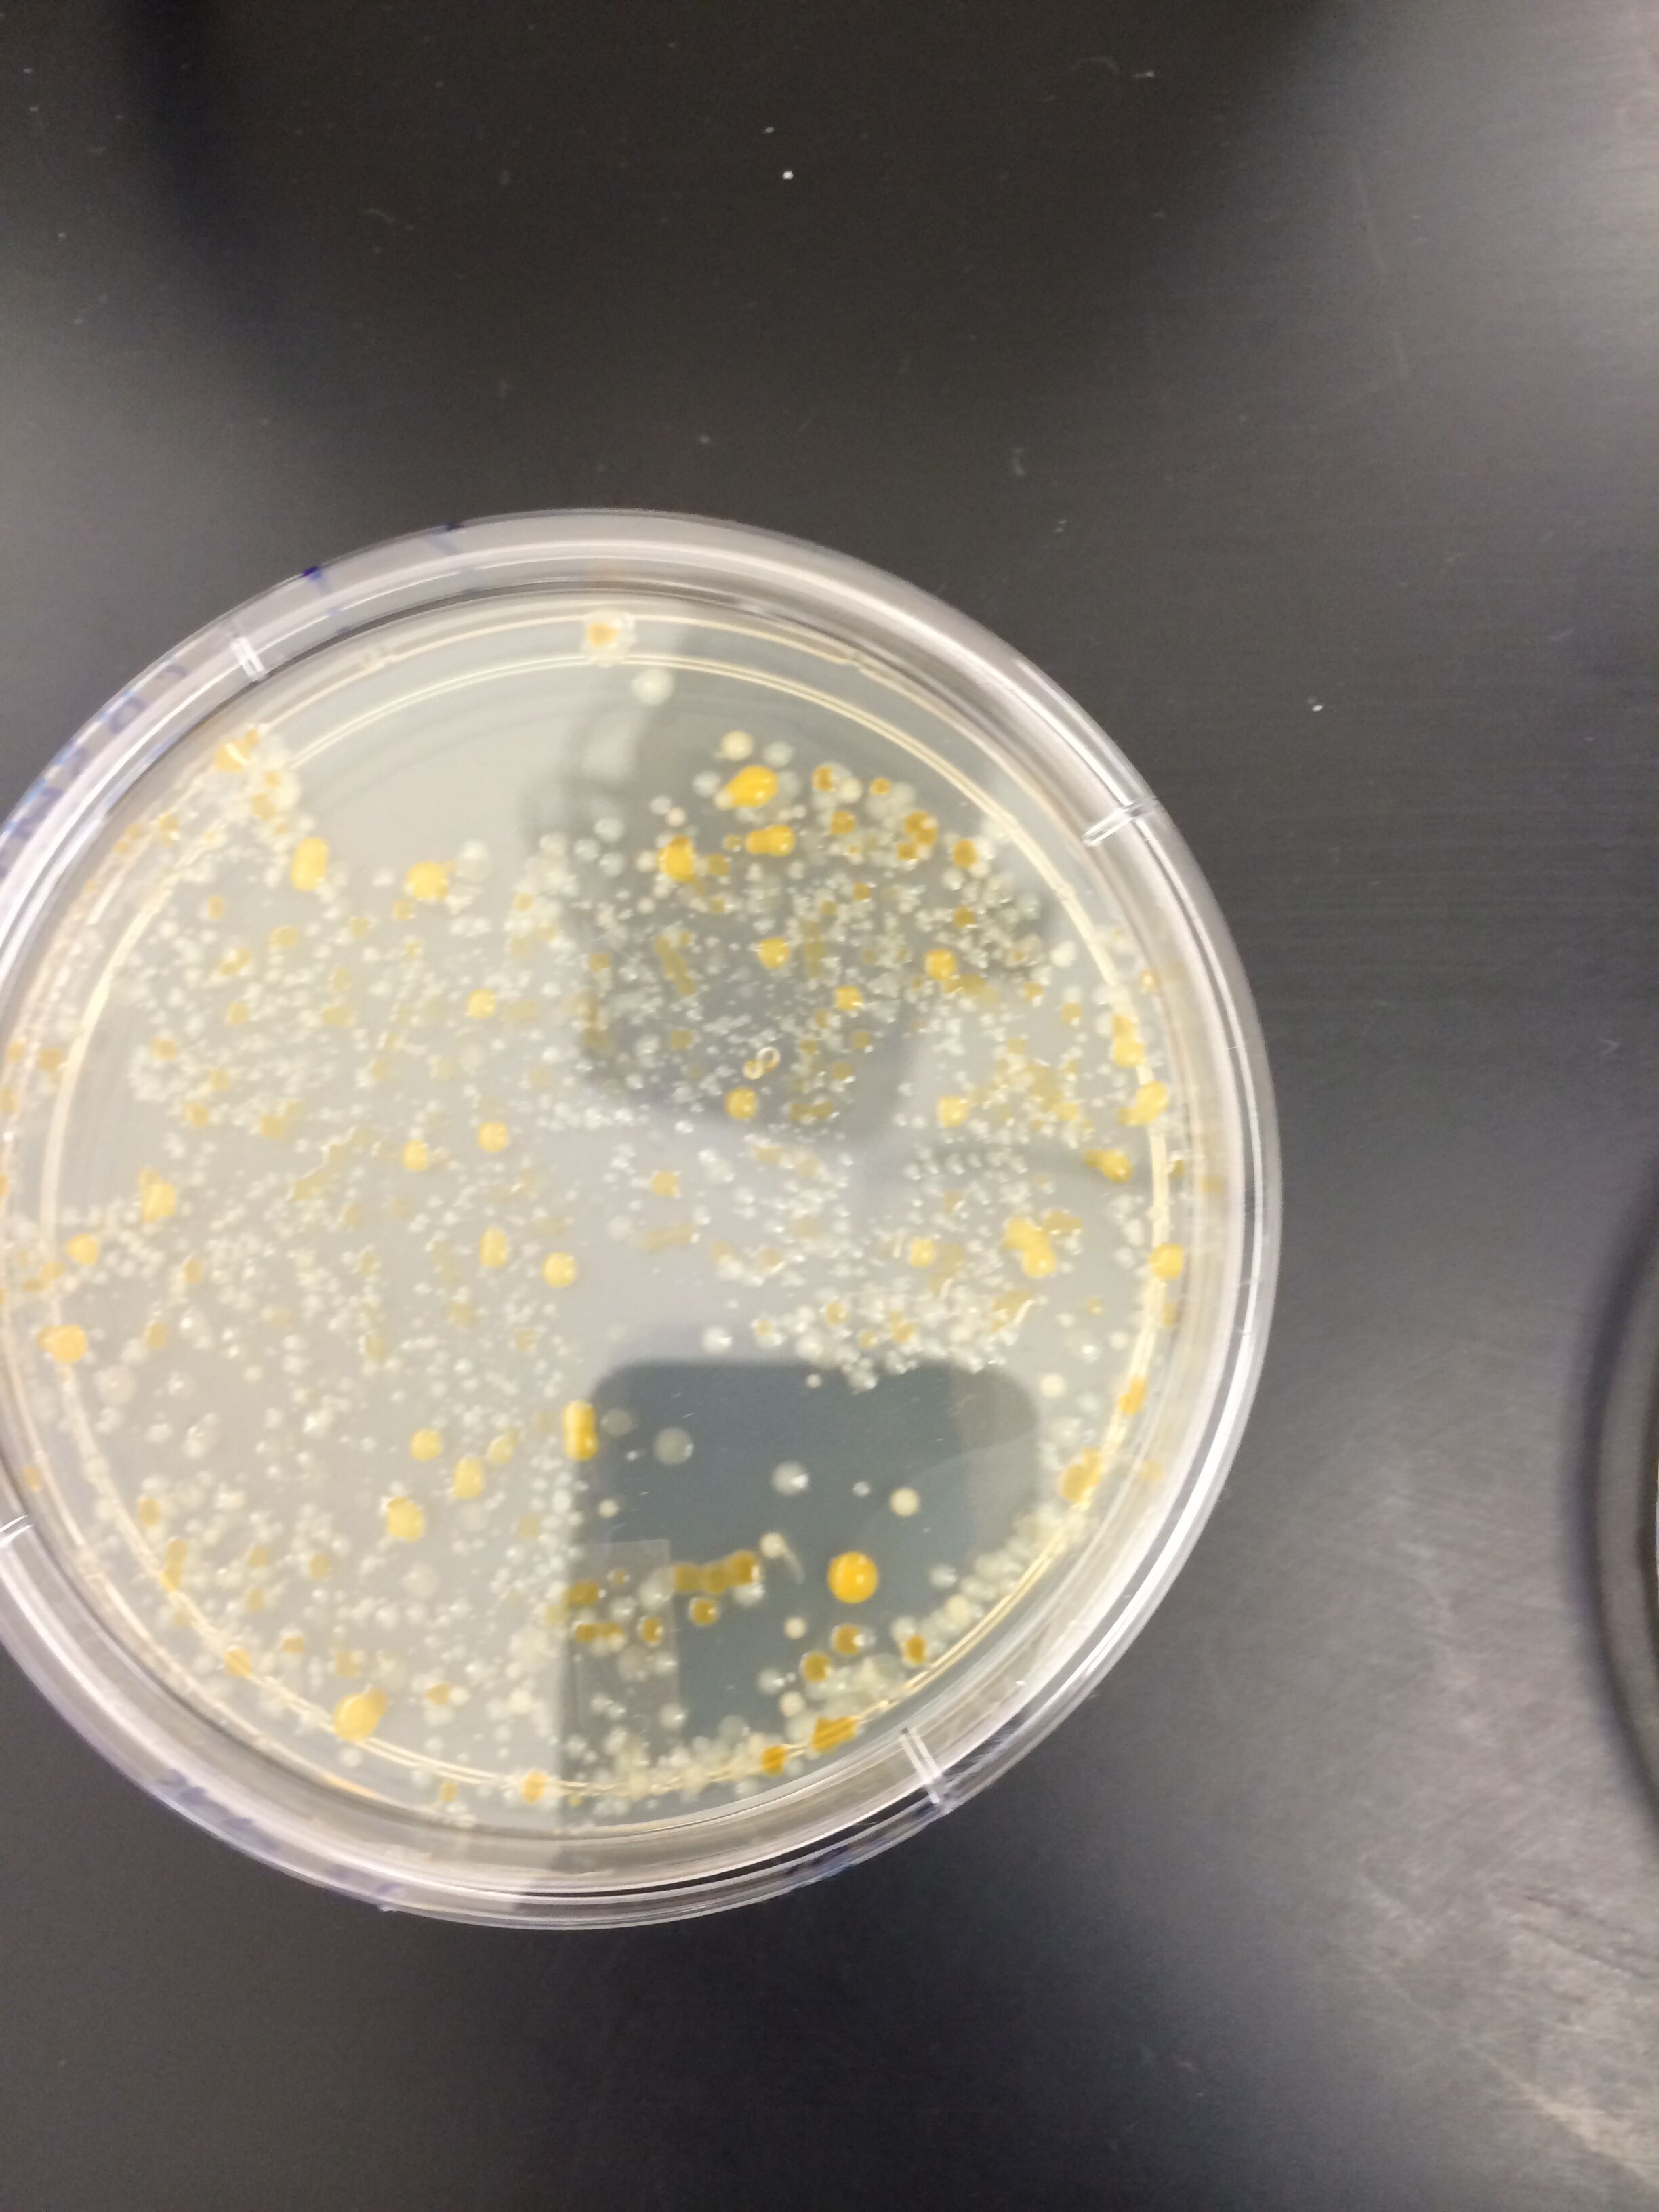
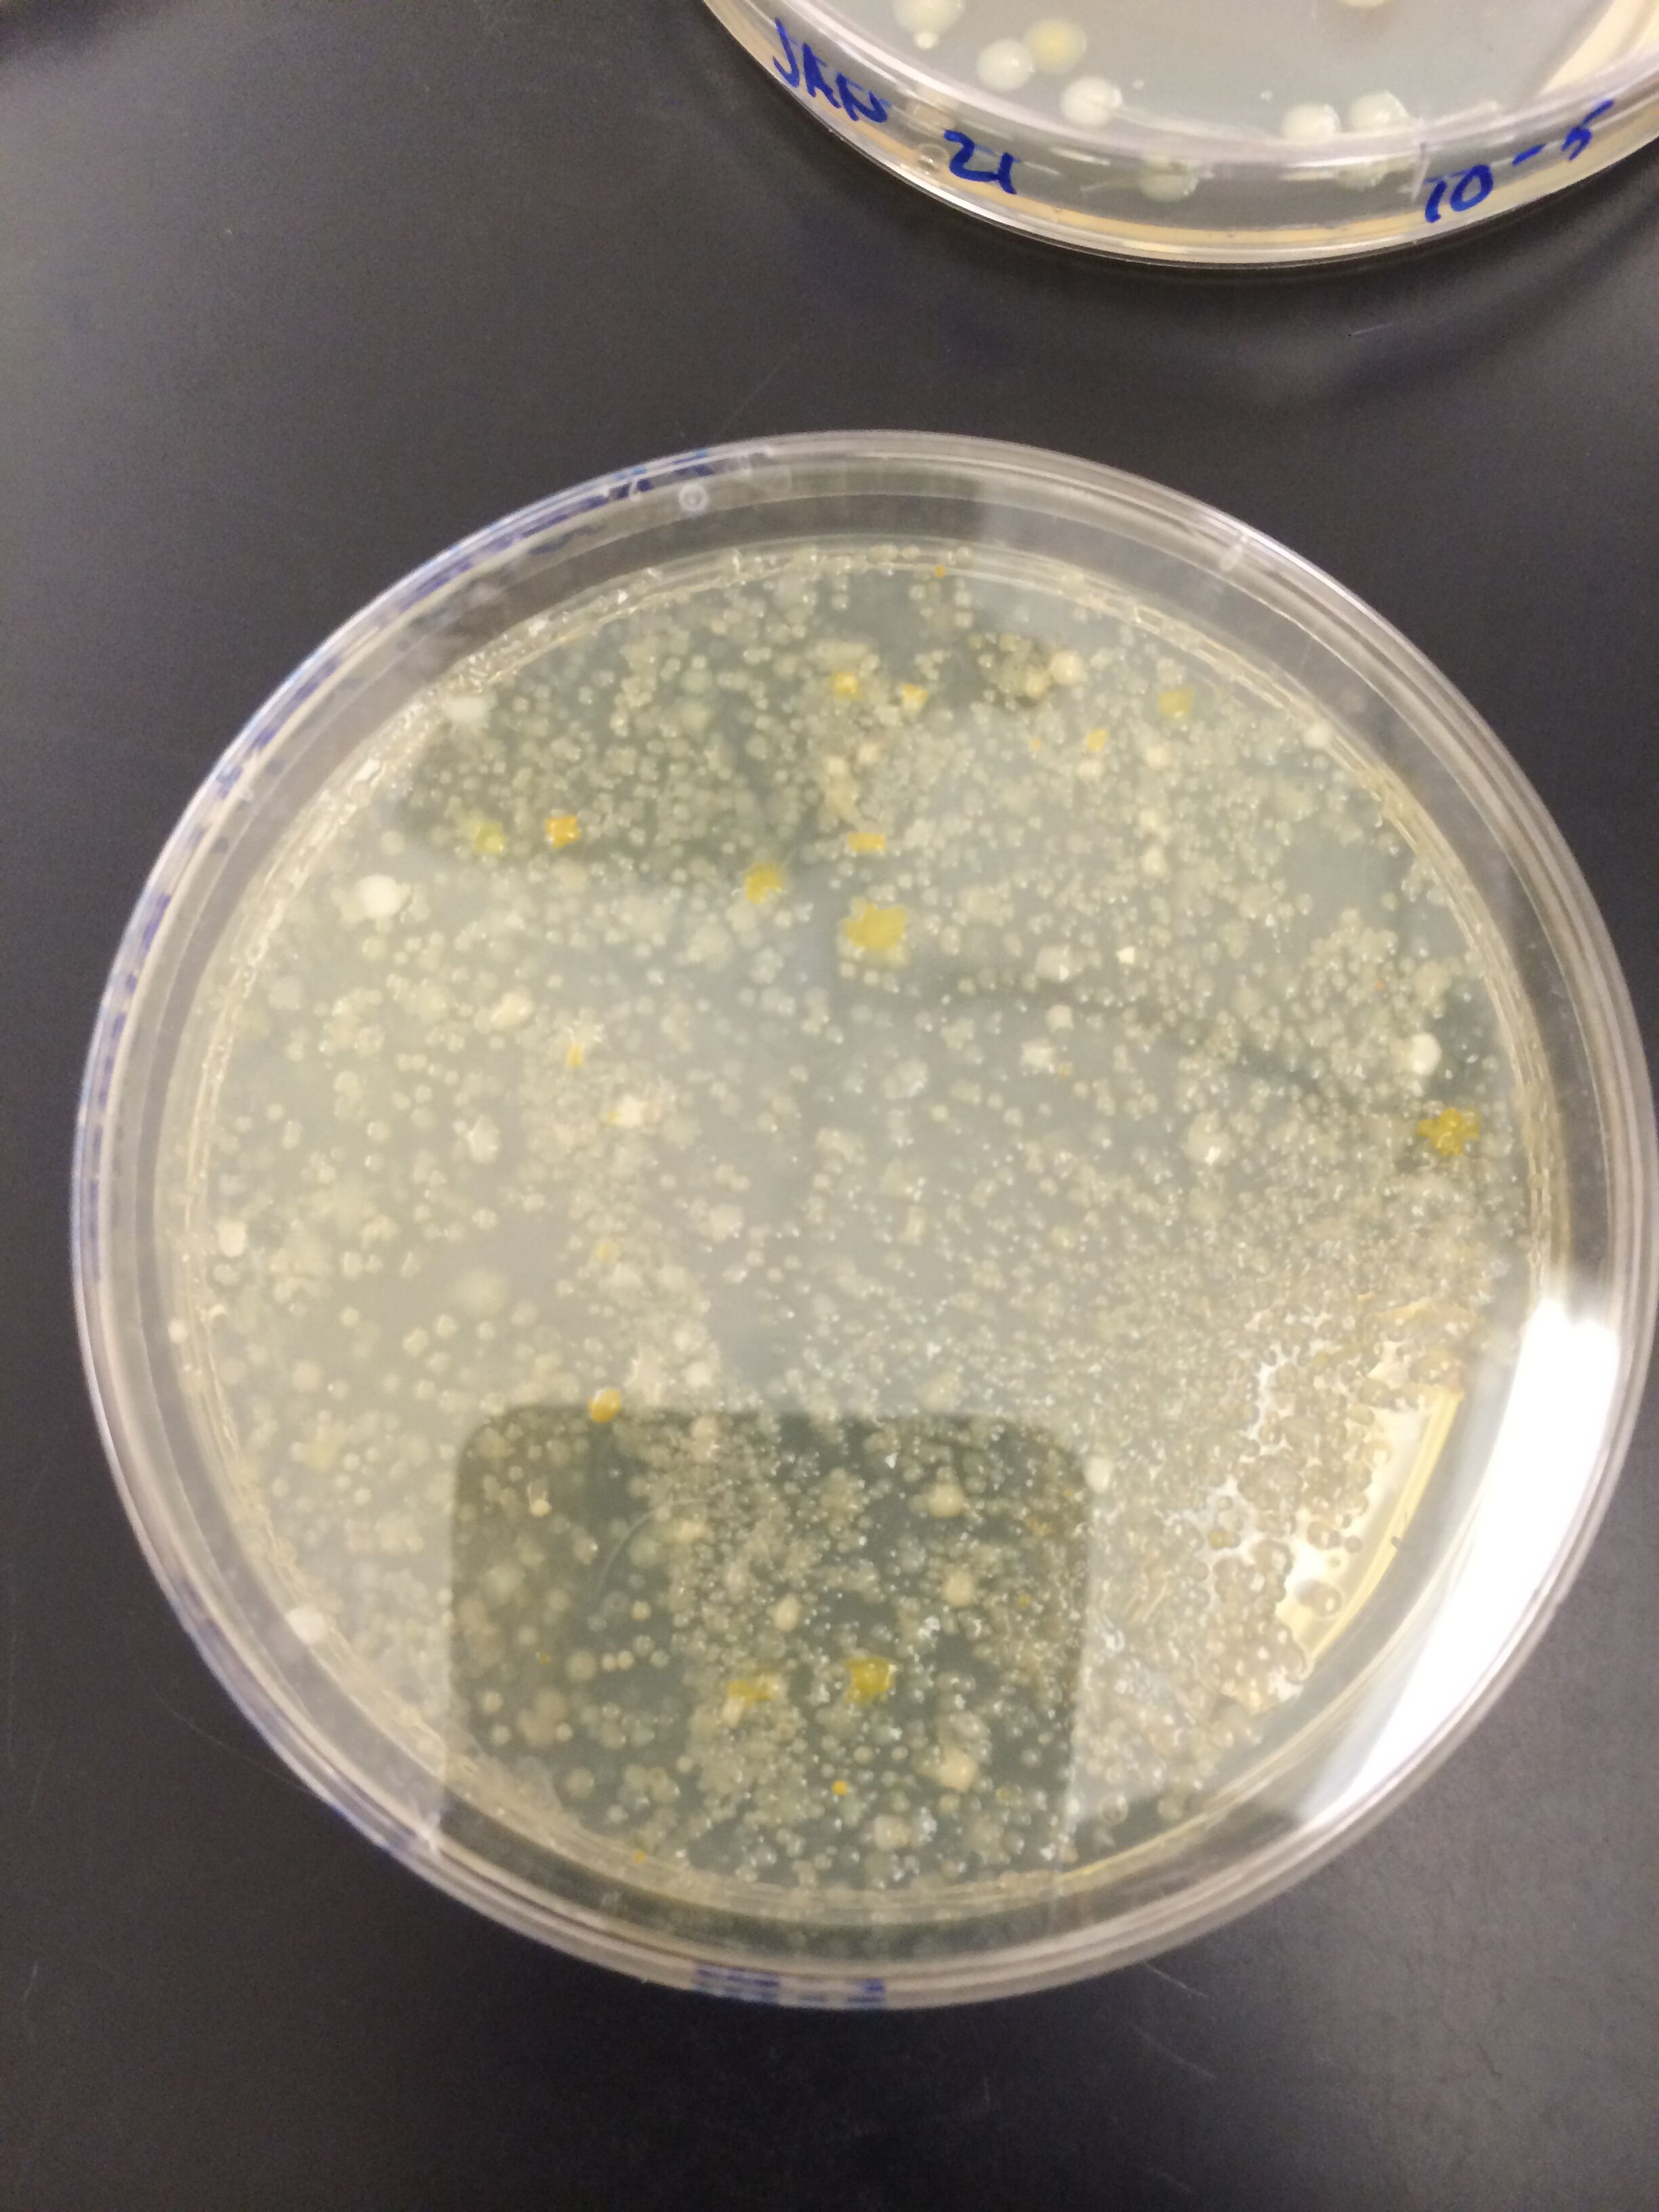
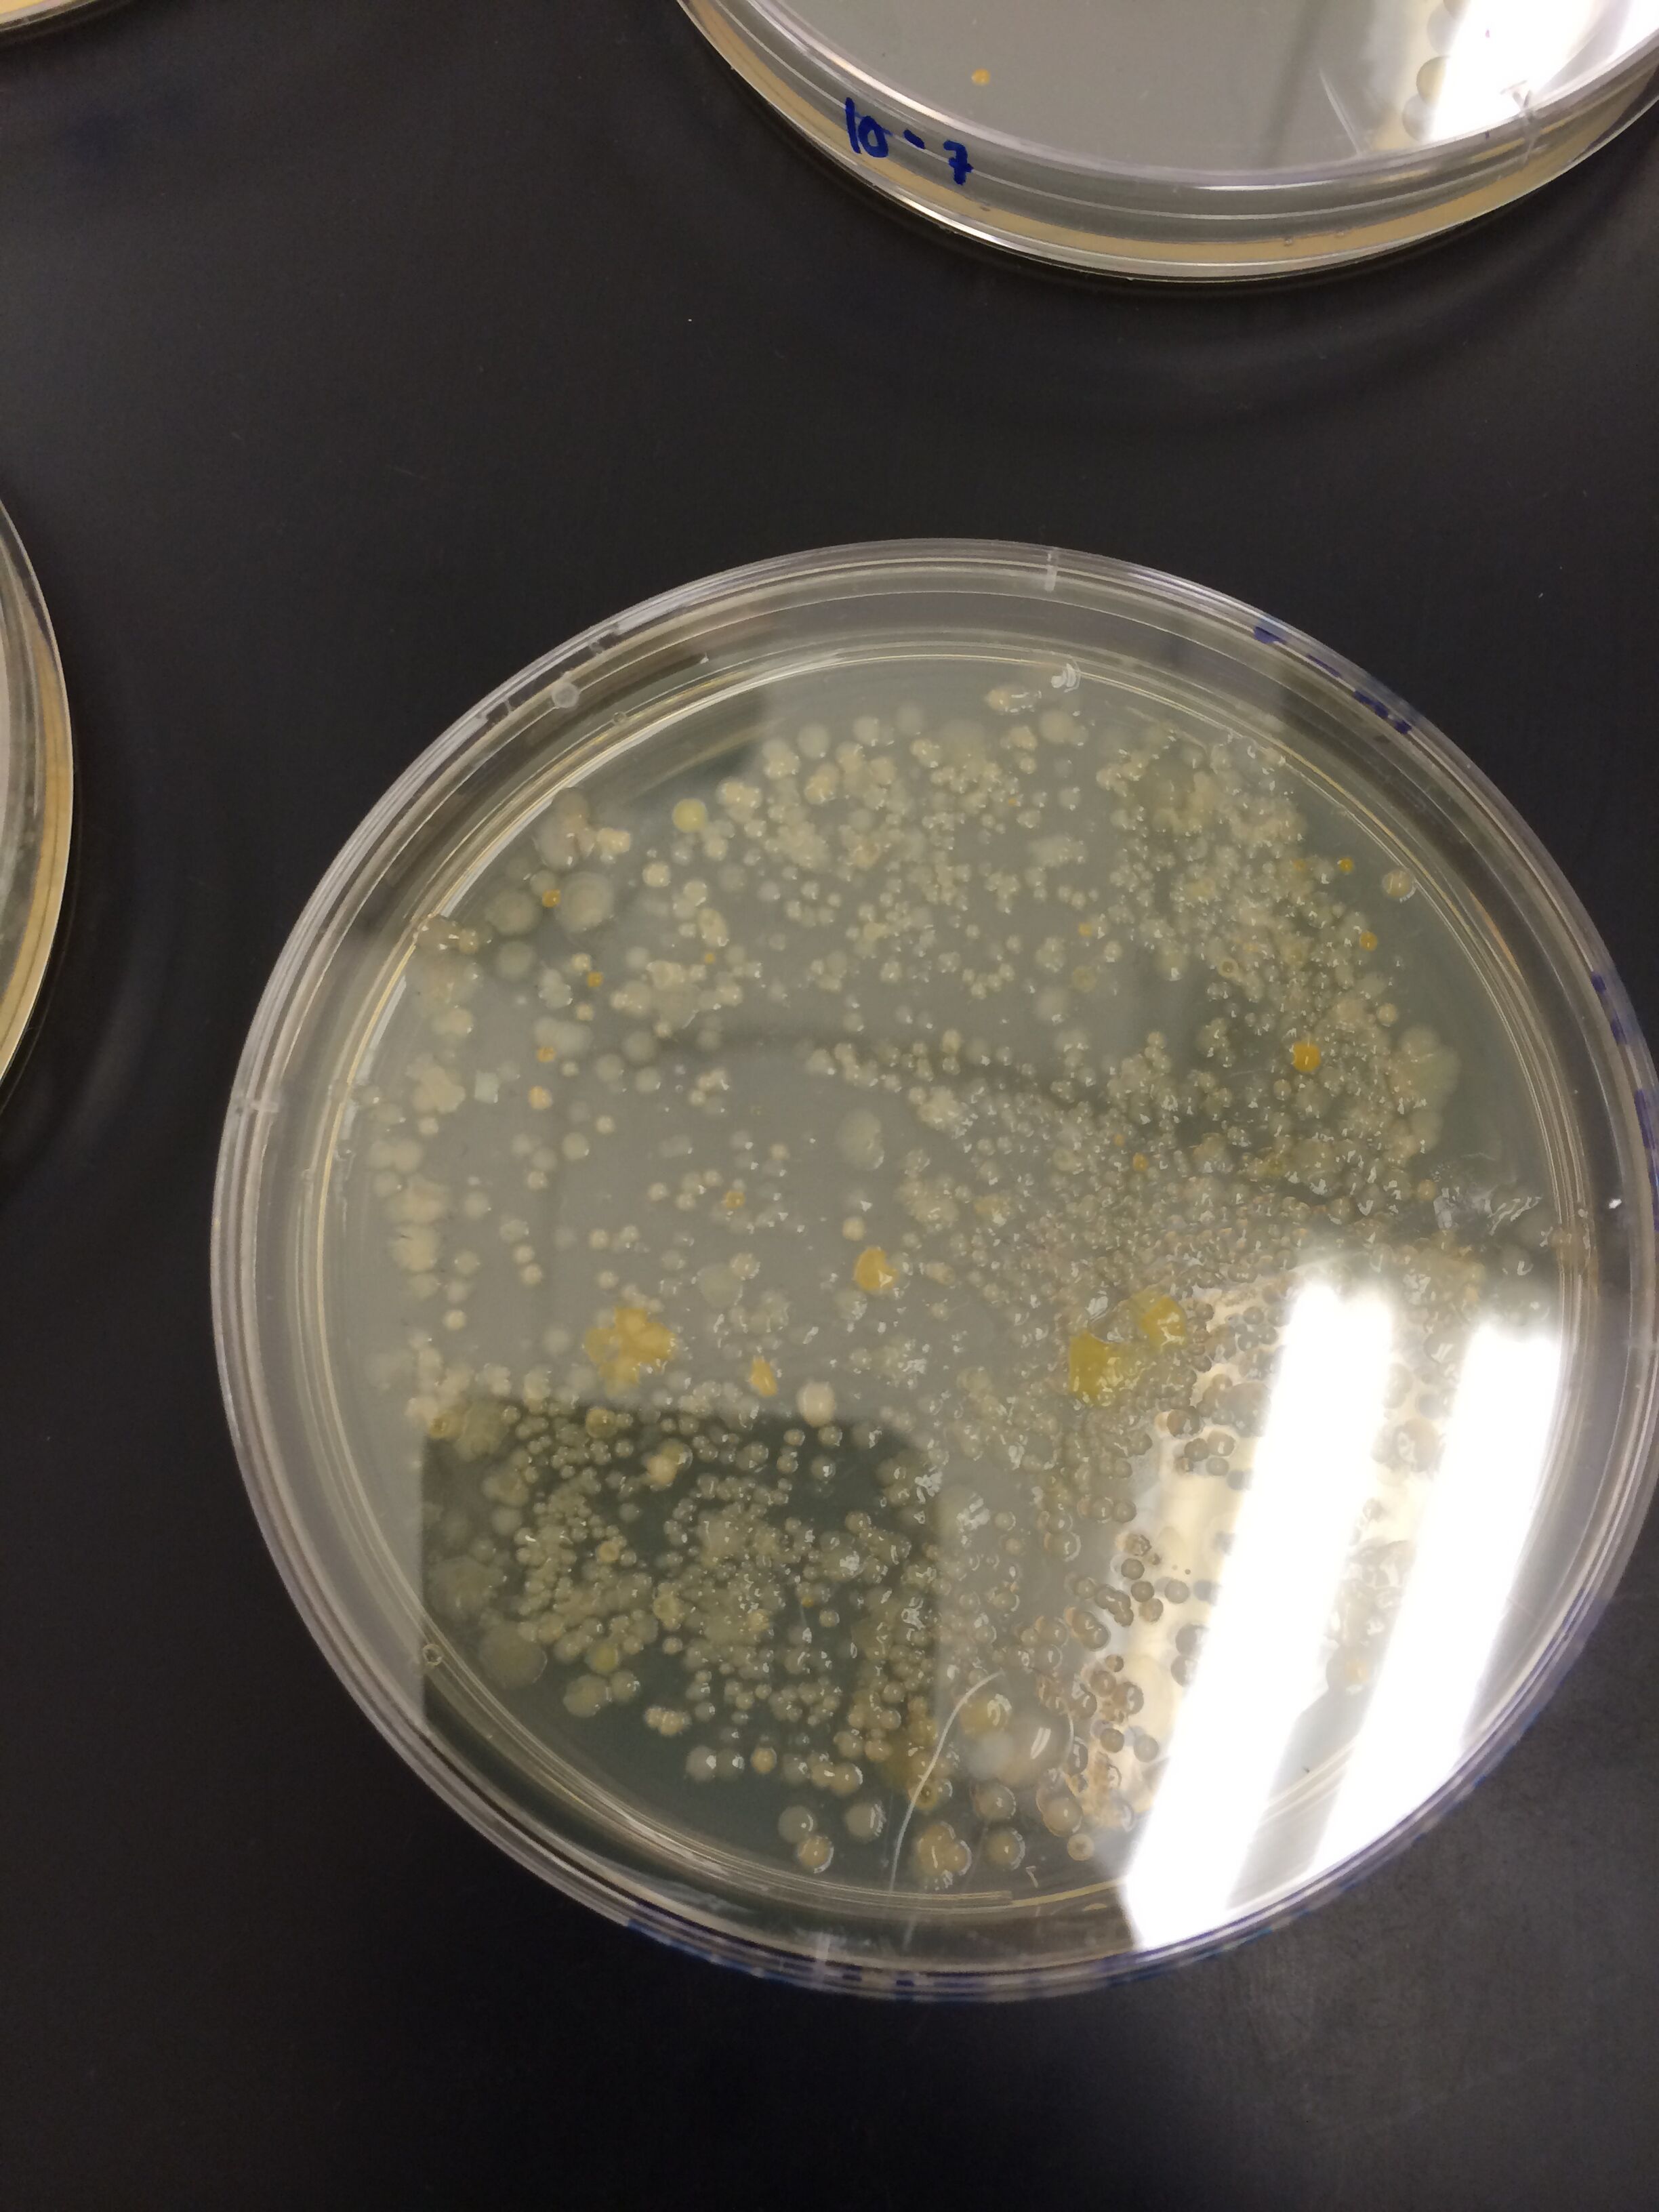
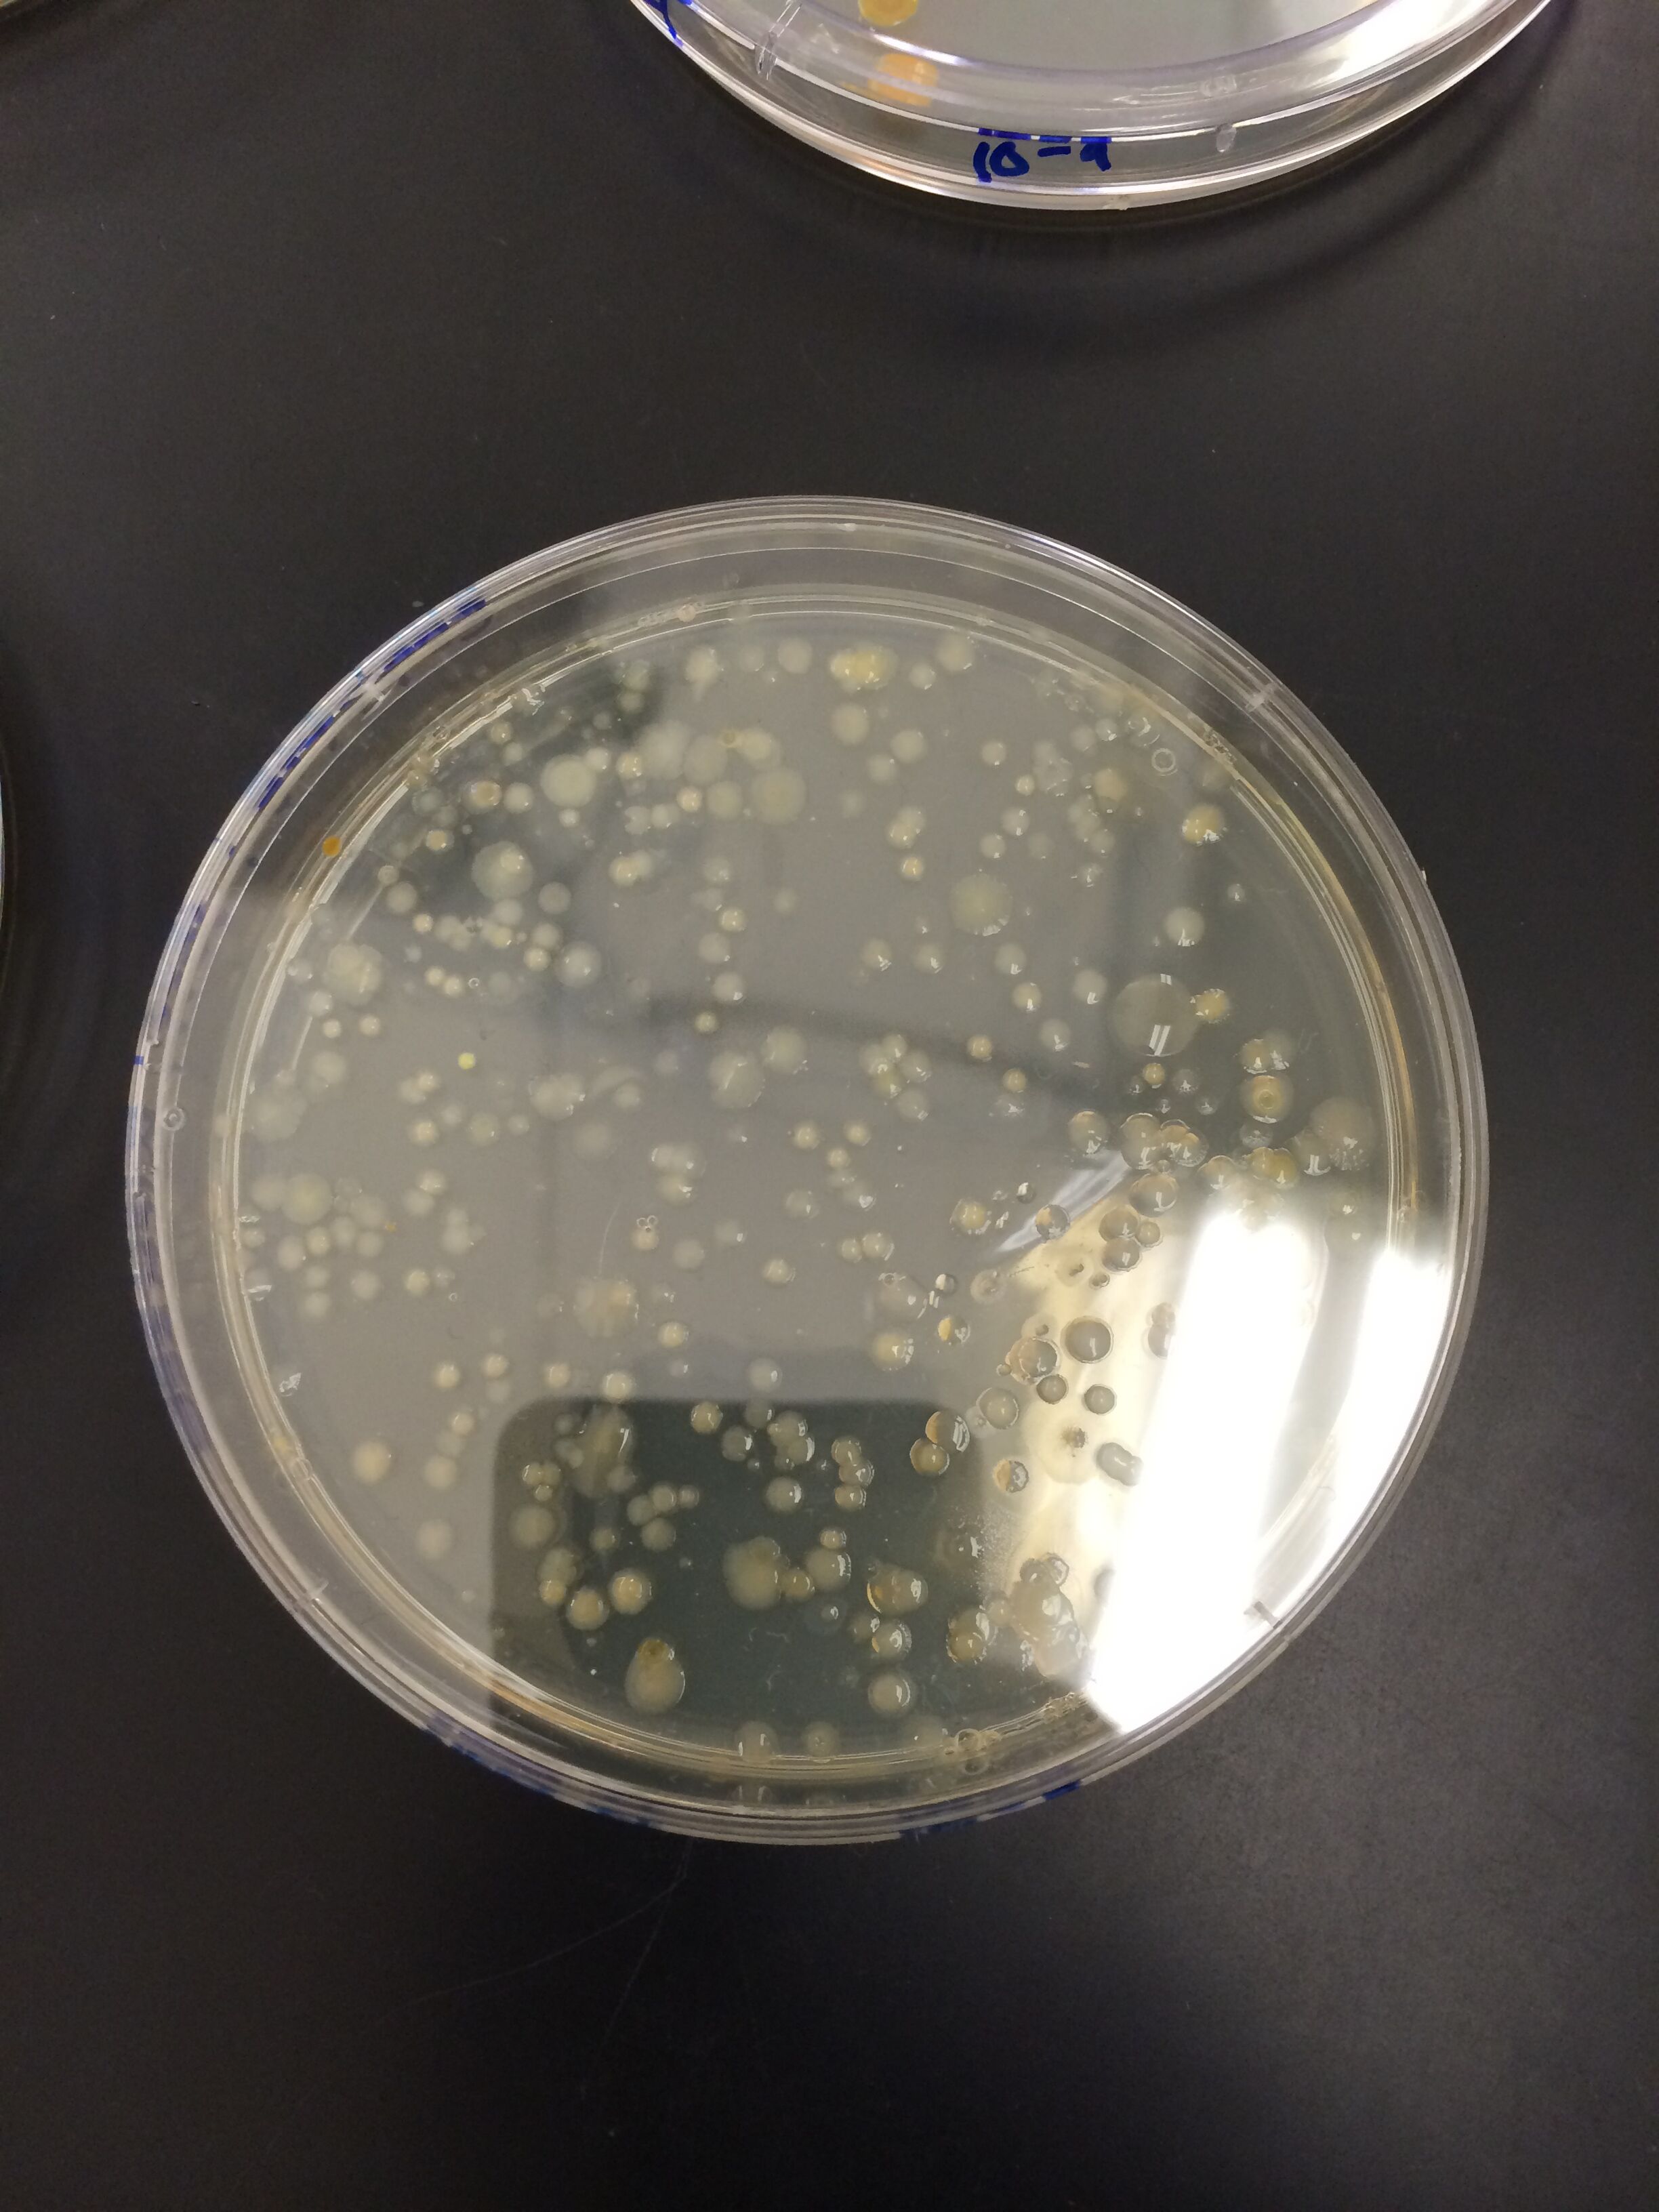

User:Michael Robert Eckhart/Notebook/Biology 210 at AU
3/16/2015 -ME
Introduction
The purpose of this experiment was to identify the effect of Sodium Fluoride (NaF). We expieremented on zebra fish. My hypothesis was that NaF can cause malformations in development from an embryo. If my hypothesis is correct then we will see malformations in the zebra fish.
Data and Results
<style type="text/css">
table.tableizer-table {
border: 1px solid #CCC; font-family: Arial, Helvetica, sans-serif;
font-size: 12px;
}
.tableizer-table td {
padding: 4px;
margin: 3px;
border: 1px solid #ccc;
}
.tableizer-table th {
background-color: #104E8B;
color: #FFF;
font-weight: bold;
}
</style>
| Control Group | |||||||||||
|---|---|---|---|---|---|---|---|---|---|---|---|
| Day | Number Dead | Number Alive | Stage | Size | Color | Eye Size | Pupil Size | Eye Movement | Eye Movement Numerical | Movement | Body Movement Numercal |
| Friday 20th | 0 | 20 | embryo, 1 cell | N/A | clear | n/A | N/A | N/A | 0 | none | 0 |
| Monday 23rd | 0 | 20 | embryo 10-somite, 2 hatched prim-22 | N/A | clear, tadpole visible | N/A | N/A | N/A | 0 | none | 0 |
| Wendesday 25th | 0 | 20 | 11 hatched prim 22 | 4000um | white and black | 280um | 120um | weak movement | 2 | weak movement | 2 |
| Friday 27th | 1 | 14 | high pec and long pec | 4300um | white and black | 300um | 124um | some movement | 3 | some movement | 3 |
| Monday 2nd | 1 | 13 | petruding mouth | 4500µm | white and black | 300µm | 125µm | weak movement | 2 | weak movement (33 moves per minute) | 3 |
| Wednesday 4th | 4 | 7 | petruding mouth | 4500um | white and black | 300um | 125um | weak movement | 2 | almost none | 1 |
| NaF Group | |||||||||||
| Day | Number Dead | Number Alive | Stage | Size | Color | Eye Size | Pupil Size | Eye Movement | Eye Movement numerical | Movement | Body movement numerical |
| Friday 20th | 0 | 20 | embryo 1 cell | n/a | clear | n/a | n/a | n/a | 0 | none | 0 |
| Monday 23rd | 0 | 20 | embryo 16-somite, 1 hatched prim-22 | n/a | clear, white and black | n/a | n/a | some movement | 3 | some movement | 3 |
| Wendesday 25th | 0 | 15 | high pec and long pec | 3250µm | white and black | 250um | 200µm | strong movement | 4 | strong movement | 4 |
| Friday 27th | 0 | 11 | petruding mouth | 3400um | white and black | 250um | 163um | strong movement | 4 | strong movement | 4 |
| Monday 2nd | 0 | 10 | petruding mouth | 3500µm | white and black | 200µm | 125µm | Strong movement | 4 | Strong movement (120 moves per minute) | 4 |
| Wednesday 4th | 0 | 10 | petruding mouth | 3500um | white and black | 200um | 125um | Strong movement | 4 | strong movement | 4 |
conclusion
malformations in eye size and total length was observed in the experimental group that was exposed to Sodium Fluoride. (NaF) although the experimental groups water was cleaner than the controls, because of the NaF. This resulted in more embryos and fish surviving because there was less bacteria and protists in the water. More fish from the experimental group survived than the control.
2/18/2015 -ME
March 4, 2015-JK PCR Analysis of Bacteria
Purpose
The purpose of this experiment was to use a PCR reaction and then a database of nucleotide sequences to identify bacteria present in the hay infusion cultures from each individual transect of land, and to determine if the PCR reaction showed the bacteria to match with our original identification the bacteria.
Materials and Methods
We used a sequence of DNA taken from bacteria grown on agar nutrient plates, which originated as a sample from our transect. We performed a PCR reaction to replicate the DNA,the DNA replicated was then copy and pasted into NCBI nucleotide blast to identify the species.
Results Species: Chryseobacterium sp. WR12 16S ribosomal RNA gene, partial sequence >MB24-For_16S_H03.ab1 NNNNNNNNNNNNNCNACNNTGCAGCCGAGCGGTANANATTCTTCCGAATCNTNNGAGCGNNNTACGGGTGCGGAACACGT GTGCAACCTGCCTTTATCTCGGGGATANCCTTTCCAAAGGAATATTAATACCCCATAACATANTGCNGGGGAAACTTGGG ATGAANACTACTTGTGGAAANGGATGGGCACGCGCCAGATTAGATAGTTGGTGGGGTAACGGCTCACCAAGTCTACGATC TTTANGGGGCCTGAGAGGGTGATCCCCCACACTGGTACTGAGACACGGACCAGACTCCTACGGGAGGCAGCAGTGAGGAA TATTGGACAATGGGTGAAACCCTGATCCAGCCATCCCGCGTGAGCGACGACGGCCCTATGGGTTGTAAACTTCTTTTGTA TGAGGAAAAACCTANGTACTTGTACCCCGCTGAANGTACTATACNAGTAAACACCGGCTAACTCCGTGCCATCACCCNCG GTACTACAGAGGGTGCGGNCGTTATCCGGATTTAATGNNTTNAAAGNGTCCNTAGGCNGANCTGTNCNTCNNNGNTGAAA TCTCATCNCTTANCTGTGANNCTGCCNTTGATACTGCANGTCTTGANTGTTGTTGAAGTANCTGGAATAANTTNTGTANC GNTGANNTGCATNNATATNACTTANAACACAANTTGCNAAGGCAGGTTACTATCCTGCNACTGACNCTNATGGACGAAAN CNTGCGNAGCGAACANGATTAAATACNNNGNNAGTCCACNCCCTACACAATGCANACTCNTTTNNNGATTNTCCGATTCN GACACTANNCCAAAGTGATAACTTANNCNCCTGNGGANTACGTNCNCANNAATGAAACTCANANGAATTGACANNNGACC CGCACNNNCGCTGGNATTANGTNGGNTNNANTTCTATNANNNTNNANGAACCTTACCATNGCCTTANNTGNNANATGACN GGNNTANNAATNAAANTTTTCNTCNGANCATTTTTTNNAANNTGCTNCATGGNTGNTCGTCNGNNNNNNNNNNNNCNNNN NNNAGGNNNATTTNNNGN
Conclusion
The bacteria was identified as a gram-negative bacteria of the chryseobacterium genus. This is a correction over our previous identification of the bacteria, which we initially had labeled as a gram-positive species. The mislabeling of the initial bacteria sample was most likely due to error in the staining process.
2/18/2015 - ME
Introduction
The purpose of this experiment was to identify the different types of invertebrates in our transect. My hypothesis is that we will find five different kinds of invertebrates in our transect. If my hypothesis is correct then we will identify five different kinds of invertebrates under a microscope.
Materials and Methods
To start the experiment we observed the the acoelomate, Planeria with the dissecting microscope. We then observed example organisms from each of the five major classes: arachind, diplpoda, chilopoda, insect, and crustacea.
The next part of the experiment was to observe the invertebrates collected by the Bersle funnel. First we poured the top 10-15 mLs of liquid and organisms in a petri dish. We then carefully, with forceps, picked out the invertebrates and observed them under a microscope. They were identified by using a Dichonimous key.
'Data and observations' <style type="text/css"> table.tableizer-table { border: 1px solid #CCC; font-family: Arial, Helvetica, sans-serif; font-size: 12px; } .tableizer-table td { padding: 4px; margin: 3px; border: 1px solid #ccc; } .tableizer-table th { background-color: #104E8B; color: #FFF; font-weight: bold; }
</style>
| organism (phylum and class) | Length in mm | number in sample | description of organism |
|---|---|---|---|
| anthropoda avachnida | 160 | 2 | 8 legs, 2 part boday hair |
| arthropoda insecta | 100 | 1 | ant like, dark body, symmetrical |
| arthopoda insecta isoptera | 75 | 1 | round, dark body, termite |
| arthopoda insecta collembola | 105 | 1 | long tail, symmetrical |
| arthopoda insecta hymenopieta | 80 | 2 | round body, dark body |
Conclusion
2/5/2015 - ME
Introduction
The purpose of this experiment was to identify the different kinds of plants in our transect and to explore the function of fungi. My hypothesis is that we will find a large variety of plants. if my hypothesis is correct then we will find a variety of dicots, monocots, non-vascular and vascular plants.
Materials and methods to start the experiment, we we walked to our transect with three Ziploc bags to collect leaf litter and five samples of plants. The samples were removed in manner that did not hurt the environment. After we removed the samples pictures were taken of where we took them for documentation. The leaf litter was made into a bersle funnel to collect invertebrates. A cross section was made from each of the plants to observe them under a microscope. from there, they were identified by the characteristics showed.
Data and observations Table 1 <style type="text/css"> table.tableizer-table { border: 1px solid #CCC; font-family: Arial, Helvetica, sans-serif; font-size: 12px; } .tableizer-table td { padding: 4px; margin: 3px; border: 1px solid #ccc; } .tableizer-table th { background-color: #104E8B; color: #FFF; font-weight: bold; }
</style>
| Transect samples | location and # in transect | Description | Vascularization | Specialized stuctures | Mechanisms of reproduction |
|---|---|---|---|---|---|
| kale | 4 | leafy grren, dicot, netty veins | v | flower | |
| corn | 4 | long green leaves, monocot, paralell veins | v | flower | |
| english thyme | 4 | small leaves, dicot, close to ground | v | flower | |
| brussle sprouts | 4 | dicot , veins, and close to ground | v | flower |
conclusion
The purpose of this experiment was to observe the diversity of life in our transect. although all plant samples observed were not vascular, the data still supports my hypothesis that there was a large variety of plant life in our transect. some future directions that i might take when doing this experiment is to use a transect that is not a garden. A garden usually only contains vascular plants, which hurt some of the diversity we were looking for. Fungi Sporangia are a type of fungi that can reproduce through mitosis and meiosis. The fungus that i looked at under the microscope is a mushroom (Basidiomycota) 2/3/2015- ME
Introduction
The purpose of this experiment was to find what kind of Bacteria life lives in our transect. We placed samples of the hay infusion, the week before, on three nutrient agar plates and three plates with antibiotic on it. We did this to observe the resistance of an antibiotic (tetracycline). My hypothesis is that there will not be any Archaea species on the agar plates. If my hypothesis is correct then I will not identify any Archaea species under the microscope.
Materials and Methods Before starting the experiment, we observed the Hay infusion culture. We took pictures of it and noted any differences in smell or appearance from the previous week. Too start the experiment, we took the pea tree dishes that have been growing for a week and counted the bacterial colonies. To get a rough estimate on the amount of colonies on the pea tree dishes, we counted ten percent of the dish and multiplied that number by ten to get a final number. We then multiplied it by a conversion factor to get colonies/mL. The data of the serial dilutions were recorded then in our lab notebook. We then chose two nutrient Agar plates and two tetracycline plates, that were made last week, and observed the under a microscope. One from each sample was a wet mount and 1 from each sample was a gram stain.
To make the wet mount, we sterilized a loop over a flame, scraped a tiny amount from the surface of the sample, mixed it with 1 drop of water on the slide, and placed a cover slip over it.
To make a Gram Stain, we sterilized a loop over the flame, scraped a tiny amount from the surface of the sample, and mixed it with 1 drop of water on the slide. we then circled the area under the sample with a red wax pencil and labeled the sides. We then heat fixed the the air dried slide with the bacterial smear side up. We then used a staining tray and covered the bacterial smear with crystal violet die. The die was then washed off with water.The bacterial smear was covered with Gram's iodine mordant for 1 minute and was then rinsed off with water again. It was then decolorized by flooding the bacterial smear with 95% alcohol for 10-20 seconds. The stain was then covered with safranin stain for 20-30 seconds and rinsed off with water again. excess water was blotted of with kimwipes.
These four samples were then observed under a microscope to identify bacteria. The observations were then recorded in our lab notebook.
We then set up for PCR sequencing. to set up the PCR, we transferred a single colony into 100ul of a single tube. It was then incubated for 10 minutes at 100c on a heat block. The samples were then placed in a centrifuge for 5 minutes at 13,400rpm. During the the centrifugation, we added 20ul or primer/water mixture to a PCR tube. We then transferred 5ul of the supernatant of my centrifuged samples to the PCR reaction and then placed in the PCR machine.
Data and Observations
Hay Infusion Culture


The Hay Infusion culture smelled the same as it did the previous week. There was a thin film of brown dirt on the top of the culture.
Serial Dilution Results Dilution Agar Type Colonies Counted Colonies/mL
10^-3 Nutrient lawn xxxxxxxx 10^-5 Nutrient 700 700*10^5 10^-7 Nutrient 550 550*10^7 10^-9 Nutrient 200 200*10^9 10^-3 Nutrient+tet 672 672*10^3 10^-5 Nutrient+tet 75 75*10^5 10^-7 Nutrient+tet 25 25*10^7 10^-9 Nutrient+tet 7 7*10^9 Bacteria Characterization Colony label Plate Type Colony Description Cell Description Gram + or - 10^-3 N Purple and circular Not motile, clumped together + 10^-3 T Circular, smaller than the Agar plate not motile, clumped together + 10^-5 N Circular, some tubed shape not motile, clumped together + 10^-5 T Purple not motile, lumped together in straight lines +
Conclusion After observing the colonies on the pea tree dishes, I noticed some differences in colony types. The dishes with the antibiotic were far fewer in colonies and had some orange colonies, where as the dishes without the antibiotic were far more numerous in colonies and did not have orange colonies. This indicates that the bacteria evolved by natural selection to be resistant to the antibiotic. The effect of the antibiotic was depleting the number of bacteria colonies. four species observed were unaffected by the Tetracycline. These species were Coccus, strepococci, bacillus, and Filamatous. The mode of action of Tetracycline is that it inhibit protein synthesis by preventing the attachment of aminoacyl-tRNA to the ribosomal acceptor (A) site1. The data supported my hypothesis, we did not find any type of Archea bacteria. Some future direction that i will take if i perform this expierement agian would be to find a better way to take pictures of the samples through the microscope, becuase it was hard to take quality pictures with the tools provided. Work cited 1. Chopra, I., & Roberts, M. (n.d.). Tetracycline Antibiotics: Mode of Action, Applications, Molecular Biology, and Epidemiology of Bacterial Resistance. Retrieved February 4, 2015, from http://www.ncbi.nlm.nih.gov/pmc/articles/PMC99026/
1/26/2015- ME
Identifying Protists and algae in our Hay Infusion
Introduction
The purpose of this experiment was to identify the different kinds of life in our Hay Infusion. The abiotic and biotic components came from the campus of American University. The specific kind of ecosystem we collected from was farmland. Abiotic are components of an ecosystem that are not living, whereas biotic are components of an ecosystem that are living. Examples of biotic components of an ecosystem are Algae and Protists.
Materials and Methods
The sample used in the experiment was collected in a test tube from the community garden. the specific type of ecosystem used was "Farmland". We then mixed dried milk powder with 500 ml of water in a jar. Ten grams of the sample was dissolved in the dried milk and water mixture to create a Hay infusion culture. The Hay infusion culture was then left alone, with the Top off, for a week. The next week we took samples from the top and bottom of the Hay infusion culture. These sample were put on a wet mount then examined under the microscope, en-search for Protists. the Protists were identified and recorded. We then serial diluted a sample of the Hay infusion culture and placed 3 sample of it in a pea tree dish to sit and grow life, for a week.
Figure 1
Figure 2
Figure 1 shows the Hay infusion culture in a jar.
Figure 2 shows the , serial diluted, Hay infusion sample in a pea tree dish.
Conclusion
Samples of the Hay Infusion culture were collected from two different niches, the bottom and top of the Hay infusion culture. We observes the samples from both niches, under a microscope and bye regular eyesight, and found protists and algae. A protist is an unicellular eukaryote that consumes nutrients. Algae is an unicellular eukaryote that performs photosynthesis. In the top niche, we found Paramecium bursil, spirostomun, and Blephanismn. At the bottom niche, we found Pandorina, Paramecium multimicrocucleatum, and paranema. All of these were protozoa and motile. None of the life found in the Hay infusion, except for the algae, photosynthesized.
The Paranema met all the needs to be described as life. It did this by, consuming nutrients provide by the Hay infusion culture. These nutrients could include microscopic bit of plant or a smaller protist. It itself is a cell because it in unicellular, therefore it meets the requirement of having cells. Many of this protist were found in the sample taken therefore, we can assume that it replicated and we can also assume that it has DNA, because for replication to occur, one must pass information onto the offspring. Lastly, it participates in evolution, because it reproduces, we could not observe the sample long enough to see changes in the organism.
If the Hay Infusion Culture grew for another two months, some changes that I would think to occur would be alot more protists. because the culture only grew for a week, only a certain amount of life was observed. Although, a selective pressures might cause the protists to reduce in number, because of lack of nutrients in the culture. this could be cause by other protists consuming all of the nutrients the culture has to offer.
1/25/15- ME
Lab 1
Biology at AU
Introduction
The Purpose of this experiment was to take samples from a specific transect, of the AU community, and observe it. Samples of the transect were also put in a Hay Infusion to grow potent life inside of it. The transect we were assigned was from the AU Community Garden. Its ecosystem type is farmland. There were many abiotic and biotic components of the transect. An abiotic component is anything that is part of an environment or ecosystem that is not living or man-synthesized. A biotic component is anything that is a part of an environment or ecosystem that is living.
Materials and Methods
Each of us were assigned to a group of three classmates and with that a transect of land at AU. We traveled to the transect and recorded observations of abiotic and biotic components of the transect. We then collected a sample of the transect and put in a Hay infusion Culture. The Hay Infusion Culture was created by adding 500 ml of water into a jar, 10 grams of a sample of the transect, and 5 grams of dried milk powder. The Hay Infusion Culture was left to sit, with the lid off, for a week.
Results The Abiotic components of my transect are wood planks, fencing, rocks, snow, wire tubes, and soil. The Biotic components of my transect are plants, leaves, bacteria, and protists.
Conclusion
The purpose of this experiment was to observe that abiotic and biotic components of our transect assigned. We were assigned a farmland type ecosystem. The observation recorded were consistent with what we expected to be there. We did not see animals. Future direction that I may have taken would be to observe during a warmer time of the year when animals are more mobile and likely to be seen. This way we could have observed and recorded them.